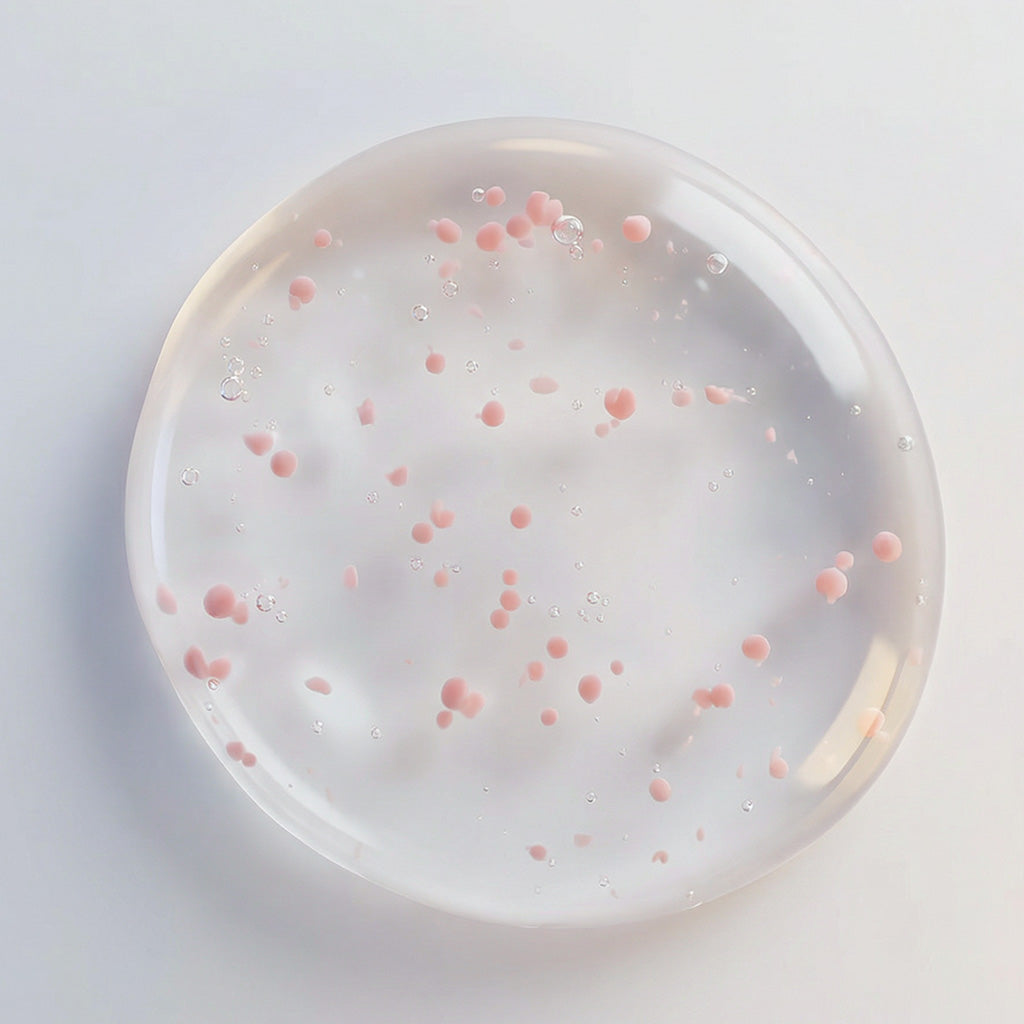
サロン ド ヒアロ オイルインセラム

Access Denied
IMPORTANT! If you’re a store owner, please make sure you have Customer accounts enabled in your Store Admin, as you have customer based locks set up with EasyLockdown app. Enable Customer Accounts
1
/
の
2
サウンドヒアロ
サロン ド ヒアロ オイルインセラム
サロン ド ヒアロ オイルインセラム
通常価格
6,600円(税込)
通常価格
(税込)
セール価格
6,600円(税込)
税込。
配送料はチェックアウト時に計算されます。
数量
受取状況を読み込めませんでした
6種類のヒアルロン酸と6種類のオイルカプセルで輝きプラス
潤いの原点
6種類のヒアルロン酸がお肌と髪にアプローチ
異なる特徴を持つ6種類のヒアルロン酸がお肌と髪のすみずみまで浸透。
健やかな状態に導きます。
ほのかに香るダマスクローズの精油
6種類のヒアルロン酸*1が奏でる
土台原液ケア
①お肌や髪の内側をうるおいで満たし、柔軟にします。
②お肌や髪のバランスを整え、効果的に成分を浸透*2させるサポートをします。
*1 保湿成分
*2 肌への浸透は角質層まで、毛髪の浸透は髪の内部まで
配合成分
水、BG、グリセリン、ペンチレングリコール、ヒアルロン酸Na、カルボキシメチルヒアルロン酸Na、ヒアルロン酸ヒドロキシプロピルトリモニウム、加水分解ヒアルロン酸アルキル(C12-13)グリセリル、加水分解ヒアルロン酸、加水分解ヒアルロン酸Na、イソステアロイル加水分解ケラチン(羊毛)、イソステアロイル加水分解コラーゲン、アルガニアスピノサ核油、クランベリー種子油、ザクロ種子油、ローズヒップ油、ダマスクバラ花油、アルギン酸Na、アルカリゲネス産生多糖体、PEG/PPG/ポリブチレングリコール-8/5/3グリセリン、ポリソルベート80、PEG-40水添ヒマシ油、PPG-26ブテス-26、カルボマー、イソステアリン酸、イソノナン酸イソノニル、酸化チタン、酸化鉄、水酸化K、フェノキシエタノール、メチルパラベン
ご使用上の注意
・お肌に異常が生じていないかよく注意して使用してください。化粧品がお肌に合わないとき、即ち次の①、②のような場合には、使用を中止してください。そのまま化粧品類の使用を続けますと、症状を悪化させることがありますので、皮膚科専門医等にご相談されることをおすすめします。
①使用中、赤み、はれ、かゆみ、刺激、色抜け(白斑等)や黒ずみ等の異常があらわれた場合。
②使用したお肌に、直射日光があたって上記のような異常があらわれた場合。
・傷やはれもの、しっしん等、異常がある部位にはお使いにならないでください。
・目に入らないように注意し、入ったときは、すぐに十分洗い流してください。
・子供や認知症の方などの誤飲等を防ぐため、置き場所にご注意ください。
・極端に高温又は低温の場所、直射日光のあたる場所には保管しないでください。
①使用中、赤み、はれ、かゆみ、刺激、色抜け(白斑等)や黒ずみ等の異常があらわれた場合。
②使用したお肌に、直射日光があたって上記のような異常があらわれた場合。
・傷やはれもの、しっしん等、異常がある部位にはお使いにならないでください。
・目に入らないように注意し、入ったときは、すぐに十分洗い流してください。
・子供や認知症の方などの誤飲等を防ぐため、置き場所にご注意ください。
・極端に高温又は低温の場所、直射日光のあたる場所には保管しないでください。
Share
Invalid password
Enter